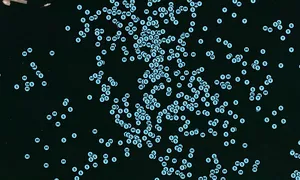

EQUINOX, MMSI: 338127602
 United States
United States
Follow the journey
Images of EQUINOX
Journey statistics
Preferred harbour type
2020
25% marina
natural harbour 75%
2019
44% marina
natural harbour 56%
2018
40% marina
natural harbour 60%
2017
35% marina
natural harbour 65%
2016
30% marina
natural harbour 70%
2015
70% marina
natural harbour 30%